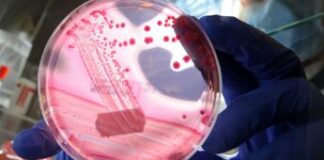
Escherichia coli in hamburger McDonald’s, 90 i casi: scoperta la causa

Tag: ultimora
Frutta secca ‘nascosta’ e shock anafilattico, rischi alti per allergia
(Adnkronos) -
Tra gli alimenti più pericolosi tra quelli che provocano allergie "primeggiano le 'nuts', dalle arachidi alle noci, ma genericamente la frutta in...
Italia-Libia, Kamel Ghribi: “Lungimirante accordo Meloni-Dabaiba, Gksd farà la propria parte”
(Adnkronos) - "L’incontro di ieri tra il Primo Ministro libico, Abuhulhamed Mohamed Dabaiba, e la Presidente del Consiglio italiana, Giorgia Meloni, è stato concreto...
Matilde Lorenzi, oggi a Giaveno i funerali della sciatrice
(Adnkronos) - Funerali di Matilde Lorenzi, la giovane promessa dello sci morta a 19 anni in un incidente in Val Senales, oggi a Giaveno...
Tonno in scatola e mercurio, Ancit: “Nessun rischio per la salute...
(Adnkronos) - Allarme mercurio nel tonno in scatola. A lanciarlo un recente rapporto pubblicato in Francia dalle Organizzazioni non governative (Ong) Bloom e Foodwatch,...
Accensione riscaldamento a Roma, via libera dal 15 novembre
(Adnkronos) - A Roma impianti di riscaldamento accesi a partire dal 15 novembre. E' quanto stabilito - in risposta alle esigenze di contenimento energetico...
Escherichia coli in hamburger McDonald’s, 90 i casi: scoperta la causa
(Adnkronos) - Svelata l'origine dell'epidemia di Escherichia coli collegata ad hamburger McDonald's, che negli Stati Uniti ha fatto registrare 90 casi con 27 ricoverati,...
Halloween, aumenti da brividi: +9,3% della spesa nel 2024
(Adnkronos) - 'Scherzetto' di Halloween: aumenti da brividi nel 2024 per festeggiare la ricorrenza più inquietante dell’anno. Tra maschere, trucchi e decorazioni, secondo l'Osservatorio...
Halloween, da ‘Frankenstein Junior’ a ‘Pearl’: i film perfetti per una...
(Adnkronos) -
Non è Halloween senza un film ‘da brividi’. Dai classici intramontabili ai cult contemporanei fino alle serie tv, il 31 ottobre è...
Ammiraglio Giuseppe Berutti Bergotto: “Mediterraneo instabile, presenti per sicurezza”
(Adnkronos) - "Attualmente la situazione nel Mediterraneo non è delle più tranquille: è un'area instabile dove ci sono parecchie crisi e dove ci sono...
Nuoro, auto finisce nella scarpata e si ribalta: morti 4 ragazzi
(Adnkronos) - Terribile incidente alle porte di Fonni, in provincia di Nuoro. Quattro giovanissimi sono morti dentro la loro auto finita in una scarpata....